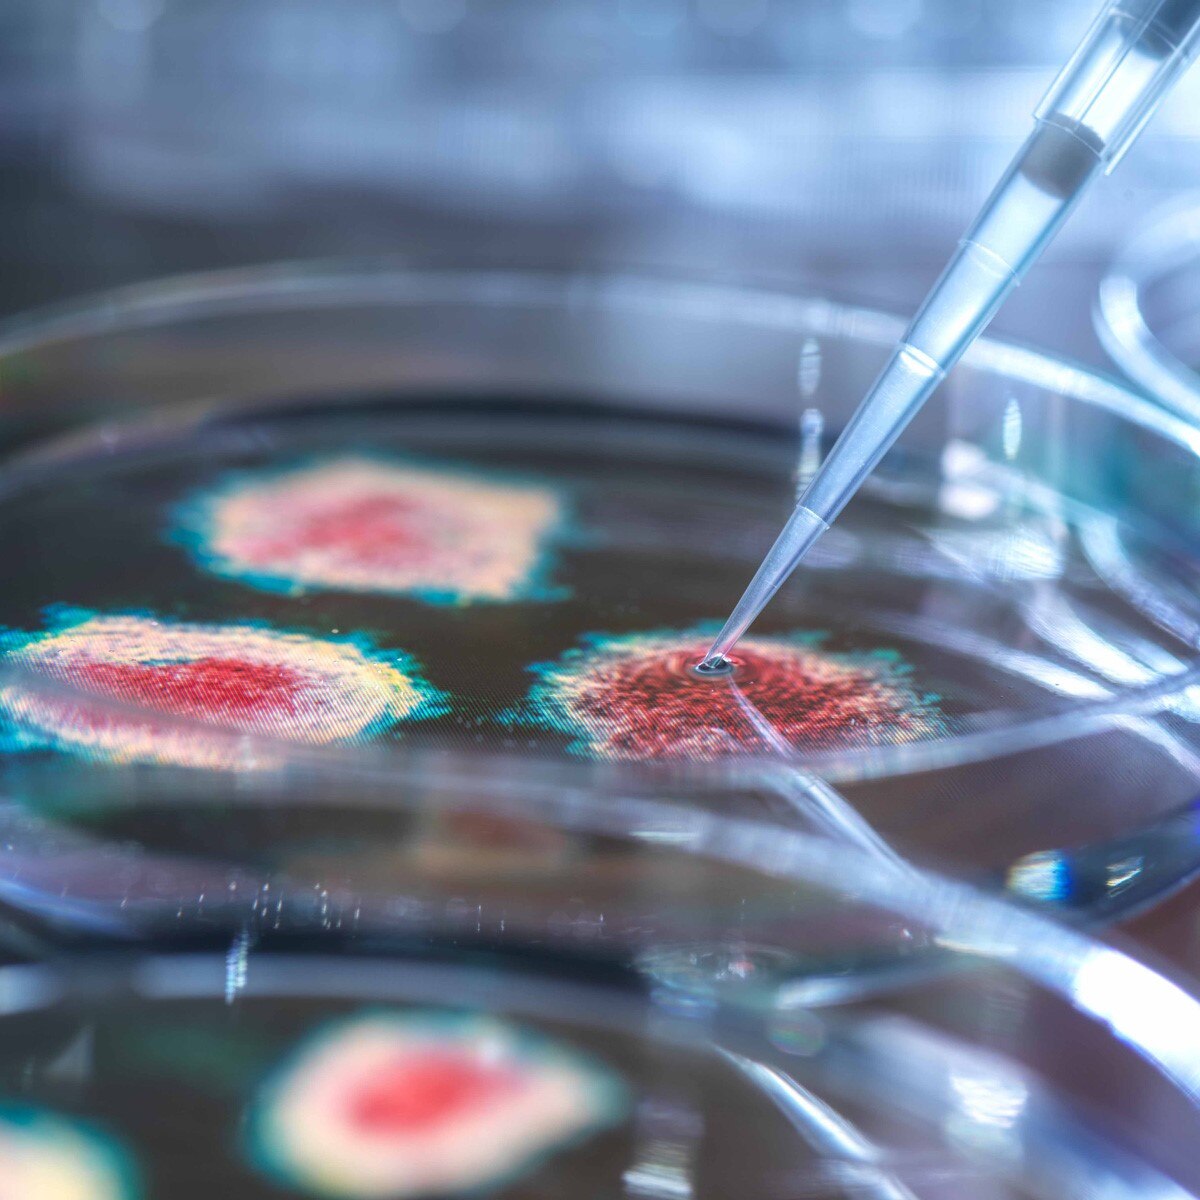
प्रतीकात्मक फोटो (Getty)

शुगर पेशेंट हैं तो कोविड-19 की थर्ड वेव से पहले हो जाएं सचेत, विशेषज्ञ से जानें वजह
कोविड-19 की दूसरी लहर के बाद अब तीसरी लहर का खतरा मंडरा रहा है. डॉक्टर कहता है कि अनियंत्रित शुगर कोविड संक्रमण में घातक हो सकती है. कोविड काल में डायबिटीज के मरीजों के लिए शुगर को नियंत्रित रखना अधिक चुनौतीपूर्ण बना दिया है, डायबिटीज यदि नियंत्रित नहीं है तो इससे कोविड का इलाज भी प्रभावित होता है. ऐसे में डायबिटीज से ग्रसित हैं और ब्लड शुगर के स्तर में लगातार वृद्धि हो रही है, तो आपको क्या करना चाहिए? एम्स के एंडोक्रिनोलॉजी और मेटाबॉलिज्म विभाग के डॉ. निखिल टंडन से कोविड और डायबिटीज विषय पर जानिए खास राय..
डॉ निखिल कहते हैं कि वायरल संक्रमण से रक्त शर्करा (ब्लड शुगर) का स्तर बढ़ जाता है. इसकी वजह ये है कि कोई भी संक्रमण या वायरल बुखार रक्त शर्करा (ब्लड शुगर) के स्तर को बढ़ा सकती है. यह मूल रूप से उस तंत्र का परिणाम है, जिसे शरीर संक्रमण से लड़ने के लिए नियोजित करता है. कुछ मामलों में, उस संक्रमण के इलाज के लिए दी जाने वाली दवाएं रक्त शर्करा के स्तर में इस वृद्धि का वजह बन सकती हैं. यदि शुगर एक सीमा से अधिक बढ़ती है, तो गंभीर अवस्था में पहुंच जाती है.
इसका एक बेहतर उदाहरण कोविड19 के मामले में साइटोकाइन स्टॉर्म है. यह अग्नाश्य द्वारा इंसुलिन स्त्राव के साथ-साथ इंसुलिन के लिए ऊतक की संवेदनशीलता दोनों को प्रभावित करता है. इंसुलिन ऊतकों में ग्लूकोज की गति को सुगम बनाता है और किसी भी खराबी (या तो उत्पादन या ऊतक संवेदनशीलता में) से रक्त में ग्लूकोज का स्तर बढ़ जाता है. कोविड19 के मामले में, मध्यम से गंभीर बीमारी वाले रोगी को स्टेरॉयड देने की आवश्यकता हो सकती है, जिससे रोगियों के रक्त में शर्करा के स्तर में भी वृद्धि हो सकती है.
क्या डायबिटीज कोविड-19 रोगियों का इलाज करना मुश्किल है? इसके जवाब में डॉ टंडन कहते हैं कि अधिकतर मामलों में, अच्छी तरह से नियंत्रित मधुमेह वाला व्यक्ति कोविड 19 उपचार के लिए उसी तरह प्रतिक्रिया करता है जैसे एक गैर-मधुमेह रोगी करता है. हालांकि लंबे समय से और खराब नियंत्रित मधुमेह वाले लोगों में या गुर्दे या हृदय रोग जैसी मधुमेह संबंधी जटिलताओं वाले लोगों में, कोविड-19 का प्रबंधन अधिक जटिल हो सकता है. ऐसे मरीजों में रोग का कोर्स अधिक गंभीर हो सकता है, जिसमें आक्रमक प्रबंधन की आवश्यकता होती है, जिसमें ऑक्सीजन, वेंटिलेटर, आईसीयू देखभाल आदि की आवश्यकता शामिल होती हैं.
ऐसे रोगियों में कोविड 19 का प्रबंधन मधुमेह के उपचार को और अधिक कठिन बना सकता है. उदाहरण के लिए स्टेरॉयड का प्रयोग जो कि कोविड 19 उपचार का एक महत्वपूर्ण हिस्सा हैं. स्टेरॉयड रक्त शर्करा नियंत्रण में महत्वपूर्ण गिरावट का कारण बन सकते हैं. इसलिए, मधुमेह के रोगियों को हमेशा गहन इंसुलिन आहार के साथ उपचार की आवश्यकता होती है. स्टेरॉयड थेरेपी के अलावा, बीमारी के दौरान कई अन्य कारक भी हैं जो रक्त शर्करा के स्तर में इस वृद्धि में योगदान करते हैं जैसे कि मरीज के आहार की आदतों में बदलाव. बीमारी का तनाव और मरीज के नियमित भोजन और व्यायाम के नियमों का पालन करने में असमर्थता भी रक्त शर्करा के स्तर को बढ़ा सकती है.
बता दें कि अधिकांश लोगों में मधुमेह एक ए-सिम्प्टमैटिक बीमारी है और ऐसे लोगों की एक अच्छी संख्या हो सकती है जिन्हें कोविड 19 संक्रमण होने से पहले अपने मधुमेह के बारे में पता नहीं हो सकता है. ऐसे कई अध्ययन हैं जो हमें बताते हैं कि खराब संसाधन वाले देशों में, मधुमेह जैसी पुरानी बीमारी वाले 50 प्रतिशत लोगों का सही उपचार नहीं किया जाता है. कई मरीज यह जानते हुए भी कि उन्हें मधुमेह है या तो चिकित्सा देखभाल का खर्च उठाने में असमर्थ होते हैं या बीमारी का ठीक से प्रबंधन नहीं कर रहे होते हैं. इसके परिणाम स्वरूप मधुमेह के लगभग आठ में से केवल एक मरीजों का रक्त शर्करा स्तर बेहतर रूप से नियंत्रित होता है. फिर ऐसे लोग भी हैं जिनको मधुमेह होने का खतरा होता है.
कुछ रोगियों में यह तनाव या हाइपरग्लेसेमिया और स्टेरॉयड जैसी दवाओं के संयोजन से भी मधुमेह हो सकता है जिससे रक्त शर्करा के स्तर में वृद्धि हो सकती है. कोविड 19 की वजह से संक्रमित मरीज में क्या किसी नई तरह का मधुमेह हो सकता है ऐसी किसी संभावना के बारे में अभी चर्चा चल रही है. सैद्धांतिक रूप से कोविड 19 भी मधुमेह का कारण बन सकता है क्योंकि अग्नाशय में ACE2 रिसेप्टर्स होते हैं जो सार्स Cov-2 अग्नाशयी बीटा कोशिकाओं में प्रवेश करने में सक्षम कर सकते हैं. इसके परिणामस्वरूप संरचनात्मक और कार्यात्मक क्षति हो सकती है हालांकि इस तथ्य का इसका समर्थन करने के लिए हमें अभी और अधिक डेटा की आवश्यकता है.
कोविड 19 के समय, यदि हम पिछले तीन महीनों का औसत ग्लूकोज की जानकारी देने वाला HBA1C टेस्ट कराते हैं और रिजल्ट में इसके स्तर में बढ़ोतरी सामने आती है तो इसका मतलब है कि व्यक्ति कोविड 19 संक्रमित होने से पहले ही मधुमेह का मरीज था. यदि HBA1C सामान्य आता है तो हमें कोविड के ठीक होने के बाद रक्त शर्करा के स्तर की दोबारा जांच करानी चाहिए. यदि इस दौरान स्टेरॉयड थेरेपी (यदि उपयोग की जाती है) को बंद कर दिया गया है, उसके बाद ग्लूकोज का स्तर सामान्य हो जाएगा. यदि बीमारी से ठीक होने या स्टेरॉयड या दोनों के बंद होने के कुछ सप्ताह बाद पोस्ट कोविड भी रक्त शर्करा उच्च रहता है, तो यह मधुमेह के कारण होने वाले कोविड की संभावना को बढ़ा देगा.
बता दें कि HBA1C टेस्ट डॉक्टरों को यह जानने में मदद करता है कि क्या कोविड 19 रोगी में उच्च रक्त शर्करा का स्तर अस्थायी है, जिसकी हमने अभी चर्चा की है. इन कारणों को समझने और बीमारी के दीर्घकालीन प्रबंधन की आवश्यकता है. पहले मामले में, जैसे ही व्यक्ति कोविड से ठीक होता है, या जब स्टेरॉयड बंद कर दिया जाता है तो रक्त शर्करा का स्तर सामान्य हो जाता है. इन रोगों को ठीक होने के बाद अपने रक्त शर्करा के स्तर को नियंत्रित करने के लिए किसी दवा की आवश्यकता नहीं होती है. लेकिन हमें इस दौरान डेली रूटीन को सही रखना होता है.
जैसे कि अभी भी कहा जा रहा है कि तीसरी लहर का संकट सामने खड़ा हो सकता है. ऐसे यदि किसी मधुमेह के मरीज को कोविड 19 संक्रमण हो जाता है तो खुद को गंभीर संक्रमण से बचाने के लिए जानिए उसे क्या करना चाहिए. डॉ निखिल टंडन कहते हैं कि मधुमेह से गुर्दे, हृदय और आंखों में जटिलताएं हो सकती हैं. ऐसे रोगियों को अधिक सावधान रहने की जरूरत है और उन्हें अपने रक्त शर्करा के स्तर को नियंत्रण में रखने के लिए हर संभव प्रयास करना चाहिए. उन्हें अपने आहार, व्यायाम और दवा के बारे में बहुत सावधानी और सतर्कता अपनानी चाहिए. सबसे महत्वपूर्ण बात यह है कि चूंकि ऐसे रोगियों में गंभीर कोविड 19 रोग विकसित होने का अधिक खतरा होता है, इसलिए उन्हें टीका अवश्य लगवाना चाहिए. वैक्सीन गंभीर बीमारी और मृत्यु दर की संभावना को काफी कम कर देता है.